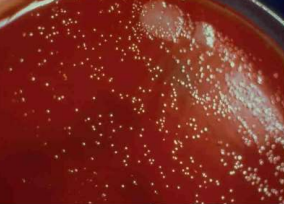

Helicobacter Gram___? Shape?
Gram negative Spiral-shaped or curved

Helicobacter Motile/Non-motile?
Flagellated, Motile
Helicobacter- Original classification
Originally Campylobacter
Helicobacter- Associated with what signs in all species?
GI tract disease
Helicobacter pylori Human disease pattern
Persistent gastritis Peptic ulcer disease Gastric adenocarcinoma (?) Gastric mucosal-associated lymphoma (?)
Helicobacter Disease range in animals
Asymptomatic to Gastritis to Cancer
Helicobacter Virulence Factors Name them
Flagella Urease Adhesins LPS CagPAI Vac CDT
Helicobacter Virulence Flagella
Motility for penetration of mucus Adherence to gastric epithelia
Helicobacter Virulence Urease
Hydrolyzes urea to ammonium **Ammonium neutralizes gastric acids** Associated with inflammation

Helicobacter Virulence Adhesins
“Saba and Baba” SabA- Sialic acid-binding adhesin BabA - Blood group antigen-binding adhesin
Helicobacter Virulence LPS
Usual Endotoxin, pro-inflammatory cytokines, O-repeats=anticomplement
Helicobacter Virulence Cag PAI Codes for what?
Cytotoxin associated gene pathogenicity island Codes for T4SS Allows CagA protein into host cells
Helicobacter Virulence Vac
Vacuolating Cytotoxin -Disrupts epithelial barrier -Pro-inflammatory
Helicobacter Virulence CDT
Cytolethal Distending Toxin -Similar to that from C. jejuni
Helicobacter - Culture conditions Aerobe/Non-aerobe
Microaerophilic (Not aerobic)
Helicobacter - Culture conditions Optimal growth temp
37C
Helicobacter - Culture Colony description
Slow-growing, flat, non-pigmented, non-hemolytic colonies.
Helicobacter - Culture conditions Fastidious?
Yes! Needs selective media
Helicobacter - Culture conditions - Selective media
Vancomycin Amphotericin Trimethoprim Cefsulodin Lysed horse blood
Helicobacter Reservoir
**Gastric mucus layer** Many animals
What percentage of dogs and cats are infected with Helicobacter spp?
80-100%
How many slaughtered pigs are infected with Helicobacter suis?
60%
Helicobacter Transmission
Oral-oral Fecal-oral
Helicobacter Zoonotic potential
Some evidence, not huge risk